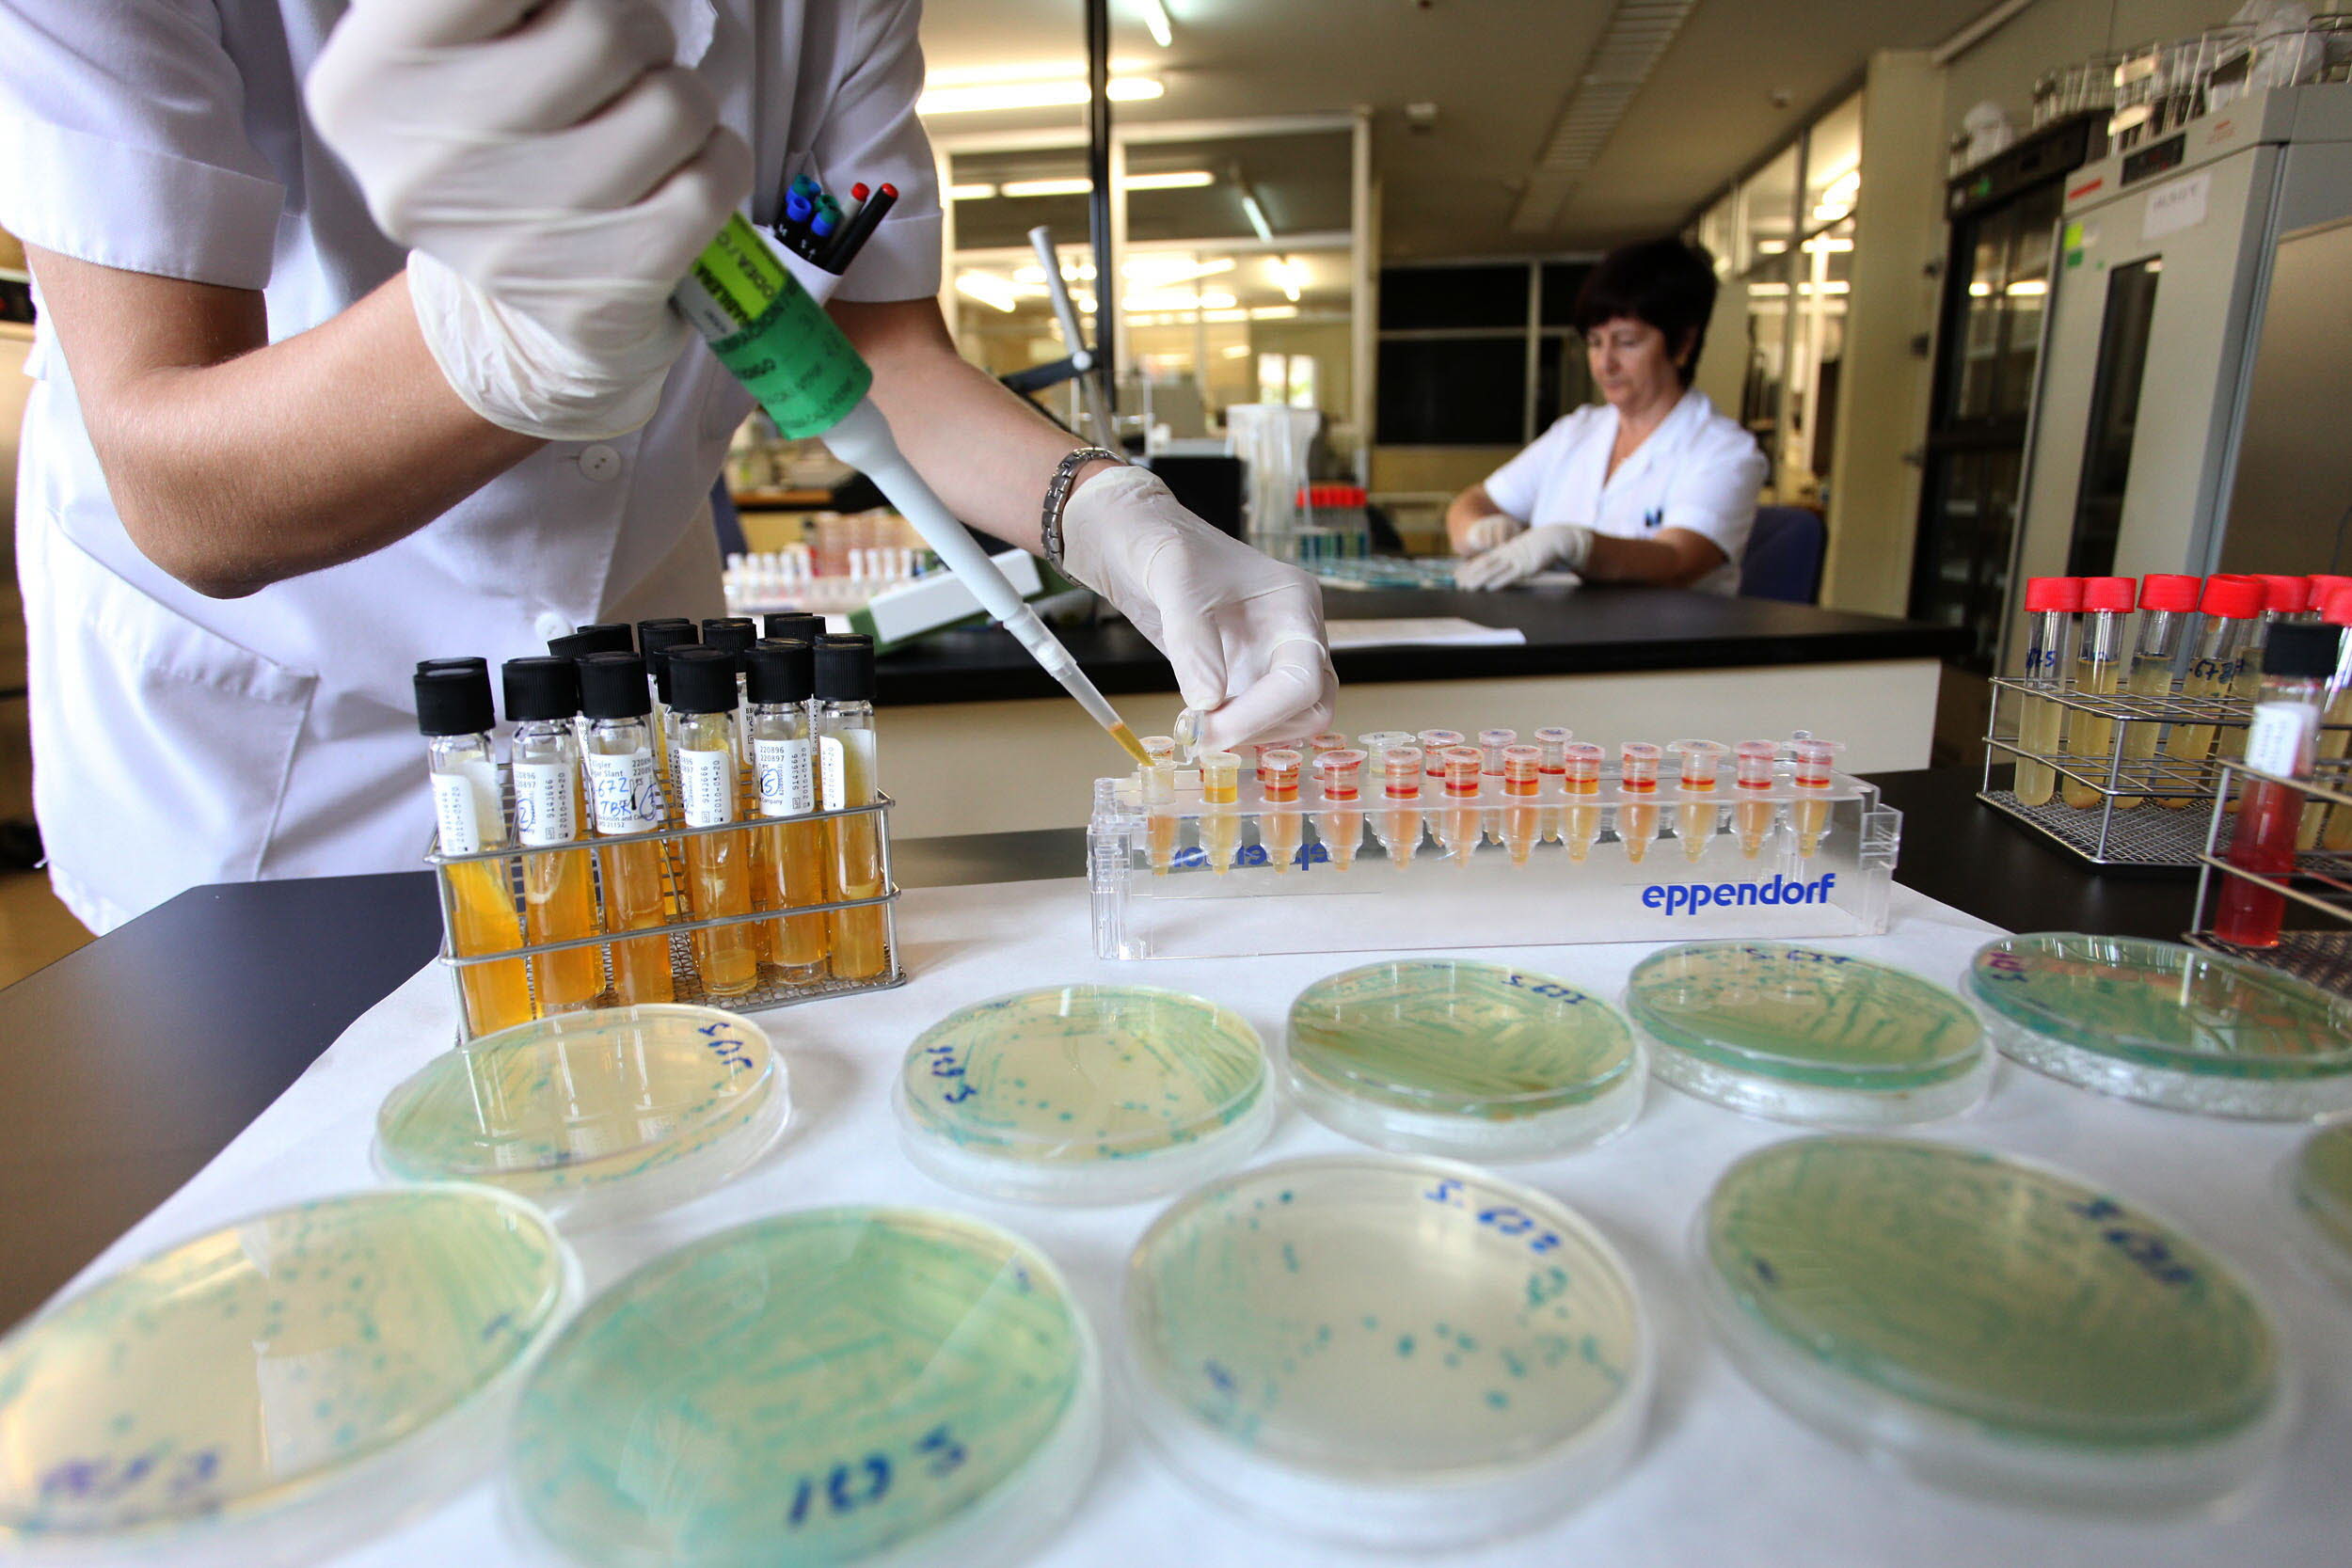
Análisis en laboratorio para detectar salmonela.

Salud incrementó un 28% los análisis para vigilar la salmonela en 2024
Con estos controles se previene, vigila y detecta la presencia de este patógeno en alimentos durante todo el procesado hasta su consumo
LA VERDAD
Domingo, 10 de agosto 2025, 12:17
La Consejería de Salud realizó 2.434 análisis durante 2024 para prevenir, vigilar y detectar la presencia de salmonela en alimentos a lo largo de todo el procesado hasta el consumo final, lo que supone un aumento superior al 28 por ciento respecto a los 1.890 efectuados en 2023, ejercicio en el que el número de controles se triplicó respecto a los 602 efectuados en 2022.
Este incremento de las muestras para la prevención y control del patógeno, llevadas a cabo por el Servicio de Seguridad Alimentaria y Zoonosis, se centró mayoritariamente en los productos del sector cárnico en mataderos y salas de despiece, en los que se realizaron 1.606 análisis para investigar la posible presencia de salmonela, de las que 106 resultaron positivas por lo que se establecieron medidas correctoras, según informaron fuentes del ejecutivo regional en una nota de prensa.
Además, 305 fueron para investigar E.coli, de las que 15 resultaron positivas; y 185 para análisis de Campylobacter, de las que 2 resultaron positivas.
Asimismo, en el resto de establecimientos y a lo largo de toda la cadena alimentaria se examinaron durante 2024 otras 828 muestras de los alimentos con mayor riesgo de transmisión de la salmonela por consumo directo, tales como embutidos, quesos, productos de pastelería, pescados, crustáceos y moluscos, frutas y verduras, helados o ensaladilla rusa, entre otros.
En este muestreo se priorizan los alimentos de mayor consumo y los más representativos de cada sector, y pese a ser los que se consumen directamente y sin tratamiento previo, tan solo se registraron 7 casos positivos durante el pasado año.
También se realizaron 525 test para detectar Listeria, con un solo positivo, y 60 para investigación de E.coli, todos ellos negativos.
CONTAMINACIÓN CRUZADA
Las inspecciones en industrias y establecimientos se centran en las actividades del procesado y manipulación de los alimentos con los que cada empresa trabaja para asegurar su idoneidad, así como en la vigilancia microbiológica para completar las garantías de los productos elaborados destinados al consumidor final.
La mayoría de las infecciones alimentarias debidas a este patógeno tienen como origen las contaminaciones cruzadas. Esto se produce cuando se manipulan productos crudos y alimentos ya listos para su consumo en el mismo espacio, como pueden ser tablas de corte o mesas de trabajo, o se utilizan los mismos útiles para ambos productos.
Cuando se produce un brote por una enfermedad de transmisión alimentaria se desarrolla una investigación en la que, según el caso, los síntomas aparecidos, el tiempo de aparición y el patógeno del que se sospeche, puede incluir la toma de muestras, tanto de los alimentos implicados como de los manipuladores que han intervenido.
Así, en 2024, con motivo de investigación de brotes, se realizaron un total de 274 muestras en manipuladores de alimentos implicados, así como 18 muestras en alimentos y 8 en superficies en contacto.
En las inspecciones realizadas se investigan las malas prácticas de manipulación, durante el procesado y elaboración de los alimentos, por las que se puedan producir contaminaciones cruzadas entre alimentos crudos y alimentos ya listos para el consumo, como principales causantes de la presentación de brotes y otros incidentes.
MAYOR VIGILANCIA EPIDEMIOLÓGICA
La incidencia de salmonelosis experimentó un descenso en 2024 al registrar 815 casos, 206 menos que en 2023, por la que la incidencia acumulada pasa a 53,2 casos por 100.000 habitantes, frente a los 69,5 que se produjeron en 2023, según el último Boletín Epidemiológico de la Consejería de Salud. Tras incrementos de la incidencia de salmonelosis entre los años 2020 y 2023, se observa un retroceso en el número de casos registrados.
La Región de Murcia dispone de uno de los sistemas de vigilancia epidemiológica más exhaustivos gracias a la incorporación a partir de 2020 del Sistema de Información Microbiológica, por el que en el sistema de notificación regional se incluyen tanto los brotes como los casos individuales. Esto ha permitido que se incremente la capacidad de detección de casos de esta enfermedad, con el consiguiente aumento del alcance de medidas de salud pública tanto en casos individuales como en brotes epidémicos, que conllevan medidas de control específicas e inspecciones de establecimientos e instalaciones de elaboración de alimentos.
Además, la Consejería de Salud lanza una serie de recomendaciones que debe seguir la población general para evitar posibles casos de salmonelosis: realizar la compra de alimentos en un lugar de confianza, llevar a cabo una buena conservación de los productos en los frigoríficos y extremar la higiene personal y del espacio donde se manipulan y almacenan estos alimentos.